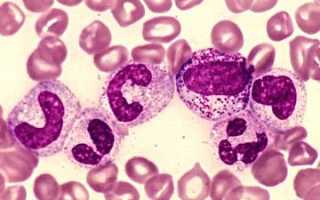

Для чего нужны сегментоядерные нейтрофилы
Эти клетки получили свое название благодаря особенностям строения ядра, которое делится на сегменты. Их количество может варьироваться от 2 до 5. Лейкоциты перемещаются по кровеносной системе, достигая различных органов. При попадании в ткани организма они «распознают» чуждые клетки и поглощают их.
В норме доля палочкоядерных лейкоцитов не превышает 6%, тогда как сегментоядерных — около 70%.
Сегментоядерные нейтрофилы играют ключевую роль в организме: они «координируют» атаку на чуждые клетки. Эти клетки способны не только перемещаться в крови, но и передвигаться по ней, используя свои «ножки», подобно амебам. Когда нейтрофил приближается к чужой бактерии, он обвивает ее. При этом он выделяет в кровь вещества, которые привлекают другие клетки, и в результате погибает.
Сегментоядерные нейтрофилы не способны уничтожать вирусы. Если у ребенка или взрослого наблюдается повышенное количество этих клеток, это может свидетельствовать о развитии бактериальной инфекции. Количество сегментоядерных нейтрофилов помогает различить бактериальные и вирусные инфекции. Иными словами, это клетки-камикадзе.
Повышение сегментоядерных нейтрофилов в крови является важным клиническим показателем, который может свидетельствовать о различных состояниях организма. Врачи отмечают, что одной из основных причин такого изменения является инфекция, будь то бактериальная, вирусная или грибковая. В ответ на внедрение патогенов организм активирует иммунный ответ, что приводит к увеличению числа нейтрофилов.
Кроме того, повышение может наблюдаться при воспалительных процессах, таких как артрит или панкреатит. Врачи также указывают на возможность увеличения сегментоядерных нейтрофилов в результате стресса, травм или хирургических вмешательств, когда организм мобилизует защитные механизмы.
Некоторые хронические заболевания, такие как диабет или заболевания сердца, также могут способствовать увеличению уровня нейтрофилов. Важно учитывать, что интерпретация результатов анализа должна проводиться в контексте клинической картины и других лабораторных данных, что позволит врачам установить точный диагноз и назначить адекватное лечение.

Нормальные содержания сегментоядерных нейтрофилов
У взрослых и детей старше шести лет уровень сегментоядерных нейтрофилов составляет от 40 до 60 процентов от общего числа лейкоцитов. У детей этот показатель варьируется в зависимости от возраста:
- у новорожденных — от 50 до 70%;
- у детей в возрасте одной недели — 35–55%;
- в возрасте двух недель — 27–47%;
- у месячного малыша — 17–30%;
- у годовалого ребенка — 45–65%;
- до шести лет — 35–55%.
Иногда уровень нейтрофилов может немного повышаться, что считается нормальным, например, после физической активности или эмоционального стресса, а также спустя некоторое время после обильного приема пищи. Это явление не должно вызывать беспокойства.
| Причина повышения сегментоядерных нейтрофилов | Описание | Дополнительные симптомы |
|---|---|---|
| Инфекции (бактериальные, вирусные, грибковые, паразитарные) | Организм реагирует на инфекцию увеличением количества нейтрофилов для борьбы с патогенами. | Лихорадка, озноб, боль в горле, кашель, диарея, сыпь, боль в мышцах, слабость |
| Воспалительные заболевания | Воспаление в организме стимулирует выработку нейтрофилов. | Боль, покраснение, отек, повышение температуры в области воспаления, общее недомогание |
| Травмы и повреждения тканей | Травмы и повреждения тканей приводят к высвобождению воспалительных медиаторов, стимулирующих продукцию нейтрофилов. | Боль, отек, кровотечение, гематомы |
| Аутоиммунные заболевания | Иммунная система атакует собственные ткани организма, вызывая воспаление и увеличение количества нейтрофилов. | Разнообразные симптомы в зависимости от пораженного органа (например, артрит, волчанка) |
| Злокачественные новообразования | Некоторые виды рака могут вызывать увеличение количества нейтрофилов. | Зависит от локализации и типа опухоли (например, потеря веса, слабость, боль) |
| Прием лекарственных препаратов | Некоторые лекарства могут вызывать повышение уровня нейтрофилов как побочный эффект. | Зависит от конкретного препарата |
| Стресс | Сильный стресс может временно повысить уровень нейтрофилов. | Беспокойство, раздражительность, бессонница, головная боль |
| Курение | Курение может вызывать хроническое воспаление и повышение уровня нейтрофилов. | Кашель, одышка, хронические заболевания легких |
| Ожирение | Связано с хроническим низко-уровневым воспалением. | Избыточный вес, ожирение |
К чему могут привести повышенные сегментоядерные нейтрофилы
Повышенное содержание сегментоядерных нейтрофилов у взрослых и детей свидетельствует о наличии воспалительного процесса в организме, а также о борьбе с инфекционными агентами. Это может указывать на следующие патологические состояния:
- различные бактериальные или вирусные инфекции;
- наличие туберкулеза;
- нарушения в работе щитовидной железы;
- лимфолейкоз.
Иногда у совершенно здоровых детей или взрослых наблюдается временное увеличение уровня лейкоцитов. Почему это происходит? Дело в том, что кровь в организме постоянно циркулирует.
При стрессовых ситуациях или физической нагрузке кровообращение усиливается, что может привести к кратковременному повышению нейтрофилов. Обычно после повторного анализа показатели возвращаются к норме, что означает отсутствие поводов для беспокойства.
Тем не менее, если анализ показывает значительное превышение количества этих клеток, необходимо обратиться к врачу. Игнорирование этого может привести к упущению развития серьезной инфекционной болезни, что чревато опасными последствиями. Как правило, повторный анализ крови помогает выяснить, что происходит в органах и тканях. Если результаты остаются плохими, принимаются меры для устранения причин повышения уровня нейтрофилов.
Повышение сегментоядерных нейтрофилов в крови часто вызывает беспокойство у пациентов и врачей. Многие люди связывают это с инфекциями, так как нейтрофилы играют ключевую роль в иммунной системе, защищая организм от патогенов. Однако причины могут быть разнообразными. Например, воспалительные процессы, такие как артрит или аллергические реакции, также могут приводить к увеличению их количества. Некоторые пациенты отмечают, что стресс и физическая нагрузка могут влиять на уровень нейтрофилов, что подтверждается исследованиями. Важно помнить, что интерпретация результатов анализа должна проводиться врачом, который учтет все факторы, включая общее состояние здоровья и наличие сопутствующих заболеваний.

Причины повышения значений
Когда количество нейтрофилов превышает норму, это состояние называется «нейтрофилез». В этом случае уровень этих клеток в крови превышает 75 процентов. Если в анализах обнаруживается повышенное количество миелоцитов (предшественников лейкоцитов), это указывает на сдвиг лейкоцитарной формулы влево.
Факторы, способствующие увеличению сегментоядерных нейтрофилов:
- Инфекции, вызванные спирохетами или грибками.
- Обострение воспалительных процессов, связанных с острым панкреатитом, ревматизмом или полиартритом.
- Наличие некротических участков в органах и тканях, что может наблюдаться, например, при остром инфаркте миокарда.
- Увеличение сегментоядерных нейтрофилов может произойти после недавней вакцинации против инфекций.
- Сильное алкогольное отравление, включая хронический алкоголизм.
- Наличие злокачественной опухоли, находящейся в стадии распада.
- Общая интоксикация организма.
- Поражение почечных тканей, особенно при диабетической нефропатии.
- Использование стероидных гормонов и других медикаментов, таких как гепарин.
Причины повышения уровня сегментоядерных нейтрофилов у детей
У детей наблюдаются различные отклонения в количестве сегментоядерных нейтрофилов в зависимости от их возраста. Если уровень этих клеток повышен, это состояние называется «относительный нейтрофилез» или «нейтрофильный лейкоцитоз». Обычно такое явление связано с рядом заболеваний.
Основной причиной увеличения количества нейтрофилов в крови является воспалительный процесс.
Это может проявляться в виде нагноений и абсцессов. Часто высокий уровень нейтрофилов у детей может быть вызван острым аппендицитом, перитонитом и другими серьезными состояниями.
Изменения в лейкоцитарной формуле у детей происходят не только из-за борьбы с инфекциями, но и для поддержания нормальной работы нервной системы.
Если уровень сегментоядерных нейтрофилов у ребенка слегка повышен, это может указывать на начальную стадию инфекционного процесса. Как и у взрослых, такое превышение нормы может быть вызвано физическими и эмоциональными перегрузками, а также после обильного приема пищи.
Однако значительное увеличение количества этих клеток в крови говорит о наличии инфекции. Только врач может назначить адекватное лечение в таких случаях. При подозрении на следующие заболевания лечащий врач может направить ребенка на анализ:
- бактериальные инфекции;
- воспалительные процессы в организме;
- «острый живот»;
- абсцессы.
Важно помнить, что при многих вирусных заболеваниях уровень этих форменных элементов крови может быть, наоборот, понижен.

Причины повышения у беременных
Во время беременности женщина должна регулярно сдавать кровь для анализа всех форменных элементов. Изменения в составе крови могут помочь выявить заболевания на ранних стадиях, что позволяет минимизировать риски для здоровья ребенка.
Важно отметить, что повышенный уровень нейтрофилов в крови беременной не всегда свидетельствует о наличии инфекции.
При вынашивании ребенка нормы нейтрофилов практически не отличаются от таковых у других женщин. Небольшое превышение их количества не считается отклонением. Это может происходить и после приема пищи, и в процессе работы. Относительное содержание этих клеток у беременных может колебаться от 40 до 78 процентов от общего числа лейкоцитов. Основные причины значительного увеличения количества нейтрофилов включают:
- гнойные бактериальные инфекции;
- некоторые обширные воспалительные процессы;
- вакцинацию;
- некротические изменения;
- инфекционные заболевания.
Поскольку любые инфекционные процессы представляют серьезную угрозу для беременных, становится очевидным, почему так важно регулярно проходить обследования для своевременного выявления потенциально опасных инфекций.
Как снизить уровень этих клеток
Снизить уровень лейкоцитов в крови можно только при условии своевременного лечения основного заболевания. Это связано с тем, что их повышенное количество всегда указывает на наличие инфекционного процесса в организме.
Кроме того, лечение должно быть комплексным и профессиональным. Ни в коем случае не следует заниматься самолечением, узнав о повышенном уровне этих клеток в крови, так как это может лишь усугубить состояние пациента.
Незначительное физиологическое увеличение этих элементов крови можно скорректировать с помощью правильного и регулярного питания, а также нормализации режима труда и отдыха. Обычно после этого повторный анализ показывает нормальные значения.
Таким образом, если у вас выявлено повышенное содержание сегментоядерных нейтрофилов, не стоит паниковать. Если отсутствуют симптомы инфекционного заболевания, то, скорее всего, такое изменение в составе крови является временным. Однако если врач фиксирует высокий уровень этих клеток и при этом наблюдаются симптомы болезни, необходимо незамедлительно начать лечение.
Вопрос-ответ
Что значит, если повышены сегментоядерные нейтрофилы?
Повышенный уровень нейтрофилов свидетельствует об острых локализованных бактериальных инфекциях (пиелонефрите, менингите, холецистите, ангине и др.). Пониженный уровень указывает на бактериальные или вирусные инфекции, дефицит витамина B12, апластическую анемию или острый лейкоз.
Что означают повышенные сегментоядерные?
Сегментоядерные – самая большая группа лейкоцитов. Зрелые их формы отвечают на бактериальные инфекции. Соответственно, повышаются (лейкоцитоз) при бактериальных инфекциях и воспалениях.
Какие инфекции повышают нейтрофилы?
Нейтрофилы повышаются при бактериальных инфекциях, таких как пневмония, менингит, сепсис, а также при грибковых инфекциях и некоторых вирусных заболеваниях, например, гриппе. Кроме того, воспалительные процессы, травмы и некоторые хронические заболевания также могут приводить к увеличению уровня нейтрофилов в крови.
Советы
СОВЕТ №1
Обратите внимание на свое питание. Убедитесь, что ваш рацион богат витаминами и минералами, особенно витаминами группы B, C и D, а также цинком и железом. Эти элементы способствуют поддержанию нормального уровня нейтрофилов и общего состояния иммунной системы.
СОВЕТ №2
Регулярно проходите медицинские обследования. Это поможет выявить возможные заболевания или нарушения на ранних стадиях, что позволит своевременно принять меры для нормализации уровня сегментоядерных нейтрофилов.
СОВЕТ №3
Управляйте стрессом. Хронический стресс может негативно влиять на вашу иммунную систему. Практикуйте методы релаксации, такие как медитация, йога или просто прогулки на свежем воздухе, чтобы снизить уровень стресса и поддерживать здоровье.
СОВЕТ №4
Обратите внимание на физическую активность. Регулярные физические упражнения помогают улучшить циркуляцию крови и укрепить иммунную систему, что может способствовать нормализации уровня нейтрофилов в крови.